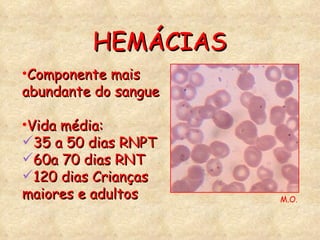
Componente mais abundante do sangue Vida média: 35 a 50 dias RNPT 60a 70 dias RNT 120 dias Crianças maiores e adultos HEMÁCIAS M.O.
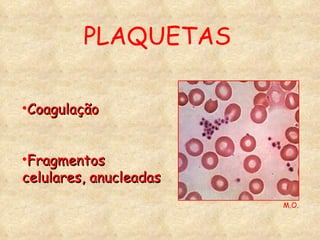
PLAQUETAS Coagulação Fragmentos celulares, anucleadas M.O.

O curso aborda formação teórica em terapia intensiva pediátrica, enfatizando hemotransfusão e componentes sanguíneos, e sua evolução histórica no Brasil. Discute indicações e contraindicações para transfusões em diferentes etapas da vida infantil, bem como reações transfusionais. Além disso, detalha os tipos sanguíneos, hemocomponentes e a importância da hemoterapia na medicina pediátrica.